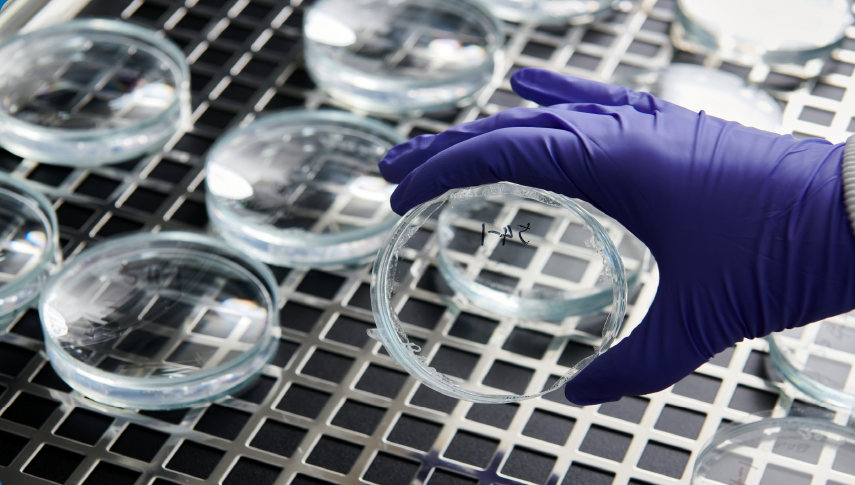

두둥~NET플릭스 아니죠~
한화솔루션 케미칼 부문만의 FLEX 시리즈 세번째 편 ,
신기술 인증 받은 XDI를 소개해 드립니다.

| 여기서 잠깐!!! 신기술 인증이란? 산업통상자원부 주최하여 산업기술혁신촉진법에 의거하여 국내에서 개발된 독창적인 신기술의 우수성을 인증해주는 제도로서, 개발된 신기술의 상용화와 기술거래 촉진과 기술 적용제품의 신뢰성을 제고시켜 초기시장 진출기반 조성하는데 기여합니다. * 당사 수상 현황: ' 22년 반도전 초고압 케이블, ‘19년 수첨석유수지 , ‘17년 XDI, ‘16년 메탈로센 촉매/CPVC, ‘14년 친환경가소제 DEHCH |
그럼, 지금부터 한화솔루션을 FLEX하게 만드는 XDI 이야기를 해볼게요.
한화솔루션의 '광학특성이 우수한 렌즈용 고순도 XDI 제조기술'이 산업통상자원부 국가기술표준원이 수여하는 'NET(New Excellent Technology) 신기술인증'을 받았습니다. * XDI (Xylylene Diisocyanate, 자일릴렌 디이소시아네이트)
XDI Story
한화솔루션의 XDI는 일반 렌즈 원료와 달리 시간이 지나면 누렇게 변색되는 황변 현상이 없고, 렌즈를 얇게 만드는데 중요한 요소인 굴절율이 높아 고급 렌즈나 디스플레이 소재, 고급 코팅제 등 광학적 특성이 요구되는 분야에 다양한 적용이 가능합니다.
현재 일본의 M회사가 독점하던 시장을 당사가 국내 최초로 국산화 개발하는데 성공 하였습니다.
XDI 기술의 핵심은 "투명성과 고굴절성"입니다.
XDI 합성 시 투명성을 떨어뜨리는 주요 원인인 불순물 정제 기술을 개발해 투명성을 높이고, 렌즈를 가볍고 얇게 만드는 핵심기술인 고굴절성을 확보하였습니다. 굴절율이 낮으면 렌즈가 두꺼워지지만 높으면 얇게 만들 수 있습니다.
흔히 압축 렌즈로 불리는 제품들이 고굴절 렌즈이며, XDI를 원료로 사용하면 기존 렌즈 보다 약 30% 더 얇고 선명하게 만들 수 있는 장점이 있습니다.
경제적 효과로는 수입에 의존하던 XDI의 국산화로 공급이 제한된 독점시장에서 안정적 원료공급으로 렌즈시장에 국내 업체들의 진입이 가능하게 되었습니다.
XDI 용도

앞으로도 한화솔루션은 R&D 을 통해 원천기술을 확보하고,
고부가가치 제품으로 석유화학/소재/에너지 산업을 이끌어가기 위해 노력하겠습니다.






* 이 콘텐츠의 모든 저작권은 한화솔루션(주)에 있습니다.